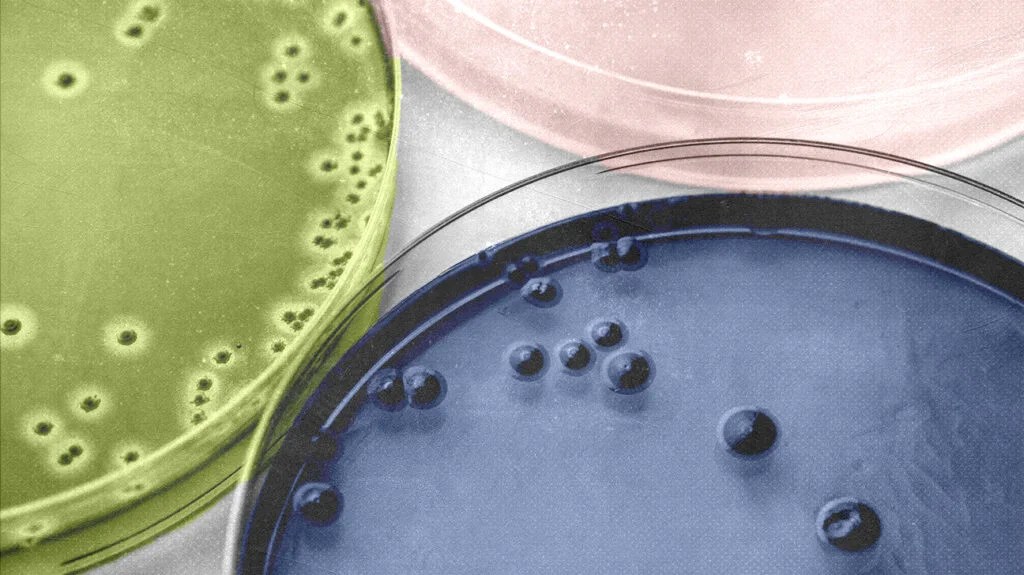

Clinical Remission in Patients with Severe Eosinophilic Asthma Treated with Benralizumab Who Were Randomised to Reduce Their Inhaled Corticosteroid/ Formoterol Dose: SHAMAL Post-hoc Analysis
This post-hoc analysis was presented by Prof. Gilles Devouassoux et al from PUPH Pneumologie, chef de service, Hospices Civils de